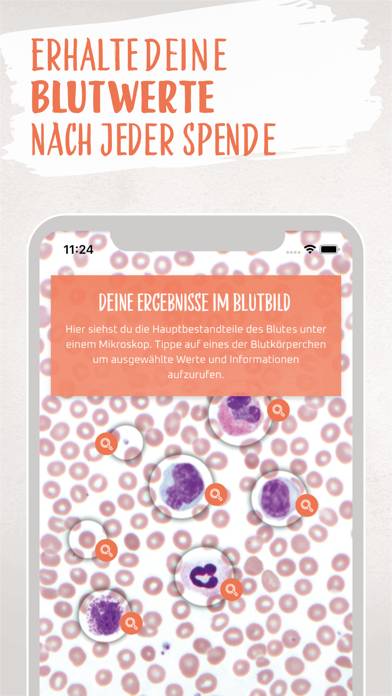

Statusplus Blutspende für iOS & Android
Published by Tricode UG haftungsbeschraenkt on Jun 01, 2020Genre: Medizin
Bewertungen: 3.74
Ausführung: 1.3.4
Aktualisiert: Sep 06, 2024
Downloads: 423
Statusplus Blutspende ist eine von Tricode UG entwickelte a medizin-App. Das letzte Update, v1.30, wurde auf September 06, 2024 veröffentlicht und wurde basierend auf den neuesten 46-Bewertungen mit 3.74 von 5 bewertet. Statusplus Blutspende ist KOSTENLOS und erfordert zum Herunterladen iOS 11.0+ und Android 10 oder neuer.

Video: Statusplus Blutspende-Übersicht
Beschreibung
Laden Sie Statusplus Blutspende herunter
So verwenden Sie Statusplus Blutspende auf Ihrem PC oder Mac
Möchten Sie Statusplus Blutspende auf Ihrem Desktop genießen? Laden Sie die neueste APK (1.30, 78 MB) herunter oder wählen Sie Ihre bevorzugte Version und folgen Sie unseren Anleitung zum Bluestacks-Emulator für eine einfache Installation unter Windows oder macOS. Wenn Sie Hilfe beim Herunterladen oder Installieren von APK-Dateien benötigen, besuchen Sie gerne unsere Foren!




